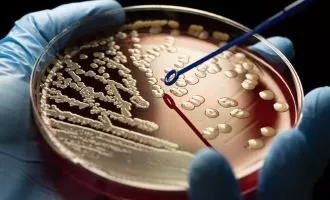

سلامت

-
سازمان بهداشت جهانی: هنوز تاثیر کرونای اومیکرون روی شدت بیماری نامشخص است
چند روز پیش سویه جدید کرونا در آفریقای جنوبی شناسایی شد و سازمان بهداشت جهانی (WHO) آن را «اومیکرون» نامگذاری کرد. با وجود نگرانیهایی که ...
![]() ۸ آذر ۱۴۰۰
۸ آذر ۱۴۰۰
-
پژوهشی از افزایش خطر ابتلا به نوعی از سرطان ریه با بیشتر شدن آلودگی هوا خبر میدهد
تیمی بینالمللی از محققان رابطهای بین افزایش آلودگی هوا و افزایش ابتلا به آدنوکارسینوم ریه (نوعی سرطان ریه) پیدا کردند. در همین مطالعه، این تیم ...
![]() ۷ آذر ۱۴۰۰
۷ آذر ۱۴۰۰
-
مولکول حاصل از یک گیاه سمی جلوی تکثیر همه گونههای ویروس کرونا را میگیرد
نوعی ماده ضدویروسی به نام «تاپسیگارگین» (TG) که از گروهی از گیاهان سمی به نام «زردکهای مرگبار» به دست میآید، ظاهرا در آزمایشگاه در برابر ...
![]() ۷ آذر ۱۴۰۰
۷ آذر ۱۴۰۰
-
پزشکی که درباره کرونای امیکرون هشدار داده بود: گونه جدید علائم غیرمعمول اما خفیف دارد
اولین پزشکی که درباره بیماران مبتلا به گونه ویروس کرونای امیکرون به مقامات بهداشت آفریقای جنوبی هشدار داده بود، در مصاحبهای اعلام کرده که علائم ...
![]() ۷ آذر ۱۴۰۰
۷ آذر ۱۴۰۰
-
مرک از اثربخشی پایینتر قرص مولنوپیراویر نسبت به مطالعات قبلی خبر داد
شرکت «مرک» اخیرا در گزارشی اطلاعات مربوط به قرص کرونای «مولنوپیراویر» را بهروز کرده و میگوید مطالعات نشان دادهاند که داروی آنها خیلی کمتر از ...
![]() ۷ آذر ۱۴۰۰
۷ آذر ۱۴۰۰
-
پای ویروس کرونای امیکرون به بریتانیا، آلمان و ایتالیا باز شد
در شرایطی که جهان فکر میکرد میتواند به شرایط عادی برگردد، شناسایی اولین موارد ابتلا به گونه جدید ویروس کرونا با نام امیکرون در کشورهایی ...
![]() ۷ آذر ۱۴۰۰
۷ آذر ۱۴۰۰
-
بریتانیا با الگوبرداری از نتفلیکس خرید آنتیبیوتیک را منوط به پرداخت حق اشتراک میکند
سرویس سلامت همگانی بریتانیا (NHS) از سال آینده میلادی طرحی را به صورت آزمایشی اجرا میکند که به موجب آن مراکز درمانی جهت تامین آنتی ...
![]() ۶ آذر ۱۴۰۰
۶ آذر ۱۴۰۰
-
هر آنچه تاکنون درباره گونه ویروس کرونا امیکرون میدانیم
گونه جدید ویروس کرونا با نام علمی B.1.1.529 بهتازگی در آفریقای جنوبی کشف و توسط سازمان بهداشت جهانی با اسم «امیکرون» (Omicron) معرفی شده است. ...
![]() ۶ آذر ۱۴۰۰
۶ آذر ۱۴۰۰
-
واکنش اپلیکیشن ماسک به جنجالهای آغاز موج ششم کرونا: حقیقت را فدای مقاصد دیگر نمیکنیم
در حالی که طی هفتههای ابتدایی آبان ماه برخی از مسئولان و اپیدمیولوژیستها خبر از آغاز پیک ششم کرونا در کشور میدادند، با وجود گذشت ...
![]() ۶ آذر ۱۴۰۰
۶ آذر ۱۴۰۰
-
محققان به روش احتمالی جدیدی برای درمان کرونا با RNA آن رسیدند
اخیرا در مطالعهای ترکیباتی شیمیایی پیشنهاد شد که میتوانند دور ساختار سه بعدی RNA ویروس کرونا چفت شوند و جلوی رشد و تکثیر این ویروس ...
![]() ۶ آذر ۱۴۰۰
۶ آذر ۱۴۰۰
-
فایزر/بیونتک و مدرنا برای تولید فوری واکسن کرونای امیکرون اعلام آمادگی کردند
فایزر/ بیونتک و مدرنا اعلام کردهاند که با گردآوری اطلاعات بیشتر درباره گونه جدید ویروس کرونا موسوم به «امیکرون» پیرامون نیاز برای تولید واکسن جدید ...
![]() ۶ آذر ۱۴۰۰
۶ آذر ۱۴۰۰
-
آسترازنکا اثربخشی واکسن و داروی کرونای خود را روی گونه «اومیکرون» بررسی میکند
شرکت آسترازنکا میگوید تحقیق درباره اثر جهش جدید ویروس کرونا بر واکسن و داروی آنتیبادی خود را آغاز کرده است. این شرکت امیدوار است واکسن ...
![]() ۶ آذر ۱۴۰۰
۶ آذر ۱۴۰۰
-
سازمان بهداشت جهانی سویه جدید کرونا را «اومیکرون» نامگذاری کرد
چند روز پیش خبری مبنی بر شناسایی گونه جدید کرونا در آفریقای جنوبی منتشر شد؛ سویهای که نگرانیهای زیادی را در پی داشت و باعث ...
![]() ۶ آذر ۱۴۰۰
۶ آذر ۱۴۰۰
-
اولین مورد ابتلا به گونه جدید کرونا آفریقایی در اروپا تایید شد
وزیر بهداشت بلژیک از اولین مورد ابتلا به گونه جدید ویروس کرونا در این کشور خبر داد که در روزهای گذشته تحت عنوان گونه ابرکرونای ...
![بلژیک]() ۵ آذر ۱۴۰۰
۵ آذر ۱۴۰۰
-
آژانس دارویی اتحادیه اروپا مجوز تزریق واکسن کرونا فایزر را برای کودکان صادر کرد
با افزایش تعداد موارد ابتلا به ویروس کرونا در کشورهای اروپایی، آژانس دارویی اتحادیه اروپا تزریق واکسن کرونا فایزر را برای کودکان ۵ تا ۱۱ ...
![واکسن کرونا]() ۵ آذر ۱۴۰۰
۵ آذر ۱۴۰۰
-
جلسه اضطراری WHO برای کرونا آفریقایی؛ بسته شدن مرز هوایی انگلیس، آلمان و ایتالیا
سازمان بهداشت جهانی از برگزاری جلسه اضطراری جهت بررسی گونه جدید ویروس کرونا که در آفریقای جنوبی کشف شده است، خبر داد. همزمان ایتالیا، آلمان، ...
![گونه جدید ویروس کرونا]() ۵ آذر ۱۴۰۰
۵ آذر ۱۴۰۰
-
کارآزمایی بالینی واکسن استنشاقی آلزایمر برای اولین بار آغاز میشود
دانشمندان اولین آزمایش انسانی واکسن استنشاقی آلزایمر را بهزودی آغاز میکنند که میتواند به جلوگیری یا کند شدن روند پیشرفت بیماری کمک کند. این واکسن ...
![آلزایمر]() ۴ آذر ۱۴۰۰
۴ آذر ۱۴۰۰
-
دردسرهای خواب خوب: هیستامین تنظیم کنندهای برای خواب
دو دهه پیش، محققان با کشف مواد شیمیایی مغز به نام هیپوکراتینها (که به عنوان اورکسینها نیز شناخته میشوند) در شناسایی نارکولپسی پیشرفت کردند. بیدار ...
![]() ۴ آذر ۱۴۰۰
۴ آذر ۱۴۰۰
-
ظهور ویروس ابرکرونای جهش یافته این بار از آفریقای جنوبی
دانشمندان گونه جدیدی از ویروس کرونا با نام Nu یا کرونای بوتسوانایی آفریقای جنوبی را کشف کردهاند که جهش بالای آن میتواند به ایجاد موج ...
![]() ۴ آذر ۱۴۰۰
۴ آذر ۱۴۰۰
-
کشف سلولهای جدید در قلب که ضربان را تنظیم میکنند
محققان نوع جدیدی از سلولها را درون قلب کشف کردند. این سلولها که به نام nexus glia ثبت شدند، به تنظیم ضربان و ریتم قلب ...
![]() ۱ آذر ۱۴۰۰
۱ آذر ۱۴۰۰

همچنین میتوانید جهت آگاهی از آخرین اخبار در حوزه تکنولوژی و اطلاع از بروزرسانی دیجیاتو مارا در شبکههای اجتماعی زیر نیز دنبال کنید. خوشحالیم که همراه ما هستید.